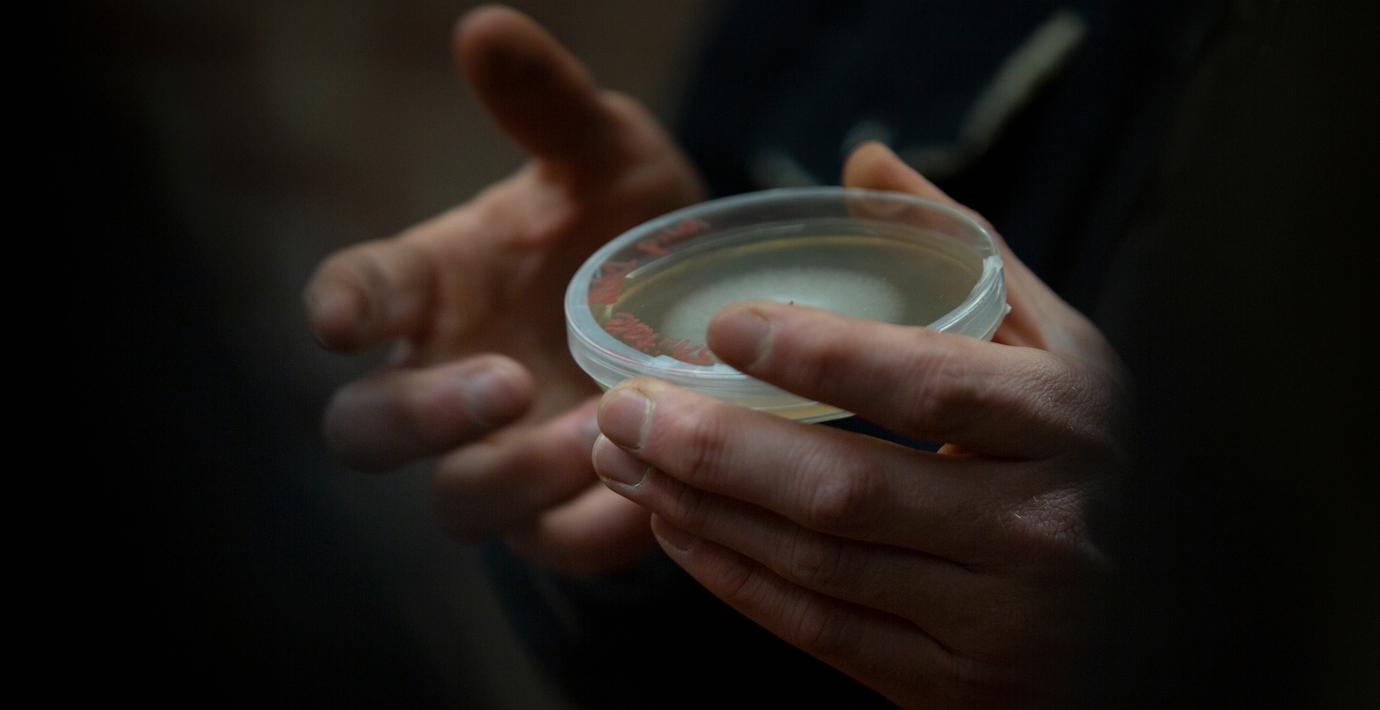

Största ägaren: Kommer att säga nej till budet på Bavarian
Bavarian Nordics största ägare Arbejdsmarkedets Tillægspension, med 10,2 procent av röster och kapital, avser inte att tacka ja till Nordic Capitals och Permiras bud. Det skriver Direkt med hänvisning till Marketwire.
Enligt Direkt har ägaren inget intresse av att acceptera budet.
Skulle Arbejdsmarkedets Tillægspension slutligen rösta nej, kommer budet att falla. För att det ska gå igenom krävs att minst 90 procent av ägarna tackar ja.
Omni är politiskt obundna och oberoende. Vi strävar efter att ge fler perspektiv på nyheterna. Har du frågor eller synpunkter kring vår rapportering? Kontakta redaktionen